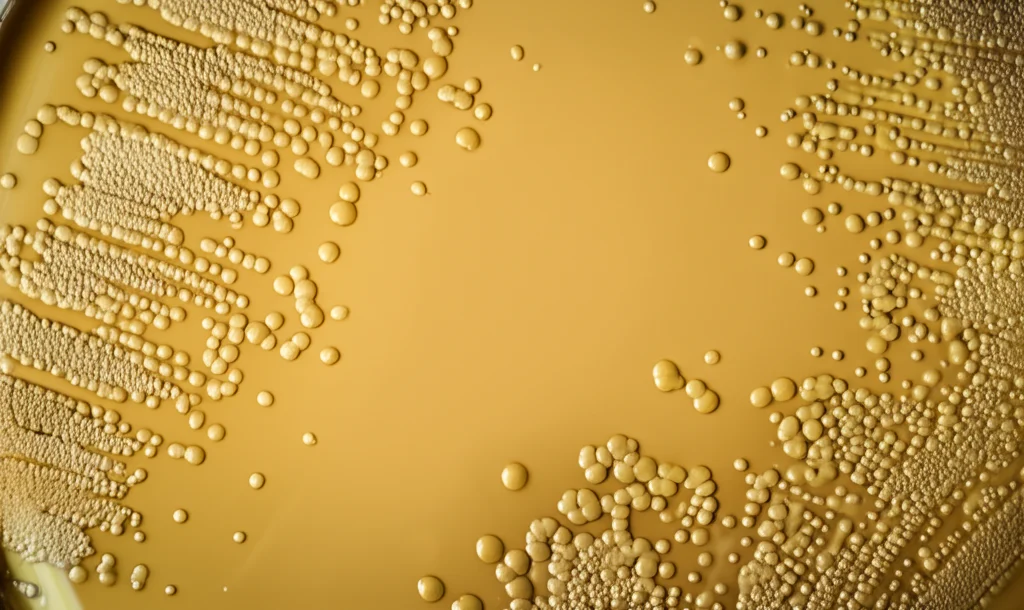
Immagine macro di cellule di lievito Meyerozyma guilliermondii su un terreno di coltura in una piastra di Petri, vista con obiettivo macro 100mm, alta definizione, illuminazione da laboratorio controllata.

Chardonnay: Il Lievito “Selvaggio” che Sussurra Nuovi Aromi al Vino
Ciao a tutti gli appassionati di vino e scoperte enologiche! Oggi voglio portarvi con me in un’avventura affascinante nel cuore del processo di vinificazione, un viaggio alla scoperta di come piccoli, anzi microscopici, organismi possano fare un’enorme differenza nel bicchiere. Parliamo di Chardonnay, uno dei bianchi più amati e diffusi al mondo, e di come possiamo renderlo ancora più speciale, più *unico*.
Sapete, nel mondo del vino moderno, spesso ci affidiamo a lieviti commerciali selezionati, i cosiddetti *Saccharomyces cerevisiae*. Sono bravissimi, fanno il loro lavoro egregiamente, garantendo fermentazioni sicure e risultati prevedibili. Ma c’è un rovescio della medaglia: questa standardizzazione può portare a vini un po’… omologati. Simili tra loro, perdendo quella scintilla di diversità, quella firma inconfondibile che lega un vino al suo territorio, alla sua *anima*.
La Ricerca dell’Originalità: I Lieviti Non-Saccharomyces
Ed è qui che entriamo in gioco noi, esploratori del microcosmo enologico! Da tempo si guarda con interesse crescente ai lieviti “non-*Saccharomyces*”, quei microrganismi indigeni, spesso presenti naturalmente sull’uva o in cantina, che partecipano alle prime fasi della fermentazione spontanea. Una volta erano visti con sospetto, oggi li consideriamo dei potenziali alleati preziosi. Perché? Perché portano con sé un bagaglio metabolico diverso, producono enzimi particolari (come glicosidasi, esterasi), precursori aromatici, glicerolo (che dà morbidezza), mannoproteine… Insomma, possono aggiungere complessità, sfumature, carattere!
Tra questi “jolly” della fermentazione, un genere che sta attirando molta attenzione è *Pichia*, e in particolare una specie chiamata Meyerozyma guilliermondii. Questo lievito è un piccolo campione nella produzione di esteri (molecole chiave per i profumi fruttati e floreali) e possiede spesso un’ottima attività β-glucosidasica. Cosa significa? Che è capace di “sbloccare” aromi che nell’uva sono legati a molecole di zucchero, rendendoli volatili e quindi percepibili al nostro naso. Immaginate di liberare profumi nascosti!
Il Nostro Protagonista: Meyerozyma guilliermondii NM218
Nel nostro studio, abbiamo messo alla prova un ceppo particolare, il Meyerozyma guilliermondii NM218. Non un lievito qualsiasi, ma un ceppo autoctono, isolato da mosti in fermentazione spontanea nel suggestivo Corridoio Hexi, in Cina. Un lievito “locale”, con una storia da raccontare. Già in laboratorio aveva mostrato grandi potenzialità, soprattutto in termini di produzione di β-glucosidasi e capacità di arricchire il profilo aromatico. Ma si sa, il laboratorio è una cosa, la produzione su scala più grande… è tutta un’altra musica!
L’Esperimento: Chardonnay Sotto la Lente
Così, abbiamo deciso di fare il grande passo: una prova di vinificazione pilota. Abbiamo preso 2 tonnellate di splendida uva Chardonnay, proveniente dai piedi del monte Helan (un’altra zona vinicola affascinante!). Dopo la pigiatura e una breve macerazione a freddo per estrarre precursori aromatici, abbiamo diviso il mosto in due “squadre”:
- Gruppo di Controllo (CK): Inoculato solo con il classico *Saccharomyces cerevisiae* (il ceppo commerciale CX9). La via tradizionale.
- Gruppo Trattato (NM): Qui la strategia è stata diversa. Prima abbiamo inoculato il nostro *Meyerozyma guilliermondii* NM218. Dopo 48 ore, quando aveva avuto il tempo di iniziare a lavorare e lasciare la sua impronta, abbiamo aggiunto anche il *Saccharomyces cerevisiae* CX9 per completare la fermentazione alcolica (AF). Questa tecnica si chiama inoculo sequenziale.
Abbiamo seguito tutto il processo con attenzione, controllando temperature (intorno ai 18-20°C), densità (per monitorare l’andamento della fermentazione) e, ovviamente, la popolazione dei nostri lieviti. Dopo la fermentazione alcolica, abbiamo avviato anche la fermentazione malolattica (MLF), un altro processo microbiologico importante per la stabilità e la complessità dei vini, soprattutto bianchi strutturati e rossi. Abbiamo prelevato campioni alla fine di entrambe le fermentazioni (AF e MLF) per analizzarli a fondo.
Cosa Abbiamo Scoperto? Sorprese nel Bicchiere!
E i risultati? Beh, lasciate che ve lo dica, sono stati davvero incoraggianti!
Il Lievito NM218 si fa sentire: Prima di tutto, abbiamo visto che il nostro *M. guilliermondii* NM218 si è ambientato benissimo! Durante le prime fasi cruciali della fermentazione alcolica, la sua popolazione è rimasta alta (sopra il milione di cellule per millilitro), dimostrando una buona capacità di colonizzare il mosto e una discreta tolleranza all’ambiente vinicolo, anche se poi, con l’aumento dell’alcol prodotto da *S. cerevisiae*, la sua presenza è diminuita fino a non essere più rilevabile a fine fermentazione, come spesso accade in questi processi sequenziali.
Chimica di Base e Colore: Dal punto di vista chimico, tutto in regola secondo gli standard. Anzi, abbiamo notato un paio di cose interessanti nel gruppo NM: un contenuto di alcol leggermente inferiore (il che può essere positivo per la bevibilità) e un contenuto di glicerolo significativamente più alto. Più glicerolo significa più morbidezza, più “corpo” al palato. Anche il colore ha mostrato differenze: i vini del gruppo NM avevano una maggiore saturazione del colore giallo (valori b* e C*ab più alti), apparendo leggermente più carichi e brillanti, e un contenuto di fenoli totali più elevato dopo la MLF, potenzialmente positivo anche per la stabilità ossidativa.

L’Esplosione Aromatica: Ma è sul fronte degli aromi che abbiamo avuto le soddisfazioni maggiori! Analizzando i composti volatili con la gascromatografia-spettrometria di massa (GC-MS), abbiamo trovato un vero tesoro. Nel gruppo NM (quello con *M. guilliermondii*), dopo la malolattica, abbiamo registrato livelli totali più alti di alcoli superiori, esteri e terpeni rispetto al controllo.
- Esteri a Go-Go: Gli esteri sono fondamentali per i profumi fruttati e floreali. Nel gruppo NM, abbiamo visto un aumento significativo di esteri chiave come l’etil caprilato (frutta tropicale, ananas), l’etil nonanoato (rosa, frutta), il feniletil acetato (rosa, miele) e l’etil laurato (floreale, cocco). Una vera sinfonia di profumi! Addirittura, il contenuto totale di esteri dopo la MLF era quasi il 12% più alto nel gruppo NM.
- Alcoli Superiori e Terpeni: Anche qui, note positive. Il 2-feniletanolo (profumo di rosa, miele), un alcol superiore molto apprezzato, era più abbondante nel gruppo NM. E dopo la MLF, anche i terpeni (come linalolo, citronellolo, geranilacetone – note floreali e agrumate) erano più concentrati.
- Note Uniche: Abbiamo persino rilevato tracce di n-eptanolo (odore oleoso) solo nel gruppo NM, e anche se sotto soglia di percezione, contribuisce alla complessità generale.
Abbiamo usato anche l’indice OAV (Odor Activity Value), che mette in relazione la concentrazione di un composto con la sua soglia di percezione. Ebbene, i vini NM mostravano valori OAV totali più alti per le serie aromatiche “floreale” e “fruttata”. Tradotto: profumi più intensi e piacevoli!
Il Verdetto dei Sensi: Le analisi sono importanti, ma alla fine è il palato a giudicare. Abbiamo organizzato una degustazione alla cieca con un panel di esperti (10 donne e 10 uomini). Il risultato? Il vino Chardonnay ottenuto con l’inoculo sequenziale (NM-MLF) ha ottenuto punteggi sensoriali complessivamente più alti. È stato descritto come più piacevolmente fruttato, con un miglior equilibrio dolce-acido, un gusto più persistente e un corpo ben bilanciato. Insomma, un vino più armonico e coinvolgente.

Perché Funziona? E Prospettive Future
Come fa questo lievito “selvaggio” a fare questa magia? Probabilmente è una combinazione di fattori. La sua capacità di produrre enzimi come la β-glucosidasi aiuta a liberare aromi “dormienti”. Il suo metabolismo produce più glicerolo e un profilo di esteri diverso e più ricco. L’interazione stessa tra *M. guilliermondii* e *S. cerevisiae* potrebbe creare sinergie positive. Certo, c’è ancora da studiare per capire tutti i meccanismi nel dettaglio, ad esempio l’origine esatta di alcuni esteri specifici trovati nel gruppo NM.
Abbiamo anche notato la presenza di 4-etil guaiacolo nel gruppo trattato, un composto fenolico volatile che a concentrazioni elevate può dare note sgradevoli (fumo, spezie medicinali). Tuttavia, nel nostro caso, la concentrazione era molto bassa, ben al di sotto della soglia problematica. È comunque un aspetto da tenere monitorato, magari durante l’affinamento del vino.
Conclusione: Un Futuro Ricco di Sfumature
Questa esperienza su scala pilota ci dice una cosa importante: esplorare e valorizzare i lieviti autoctoni come *Meyerozyma guilliermondii* NM218 non è solo un esercizio accademico, ma una strada concreta per arricchire la qualità e la diversità dei nostri vini. L’inoculo sequenziale si è dimostrato una tecnica efficace per migliorare il profilo aromatico (più frutta, più fiori!) e la piacevolezza sensoriale dello Chardonnay, senza compromettere la sicurezza della fermentazione.
È un invito a guardare oltre le soluzioni standard, a riscoprire la biodiversità microbica dei nostri territori e a usarla per creare vini con più personalità, più legati alla loro origine. Il futuro del vino potrebbe essere ancora più affascinante, un mosaico di sapori unici sussurrati da questi incredibili microrganismi. E io non vedo l’ora di continuare ad ascoltarli!
Fonte: Springer
